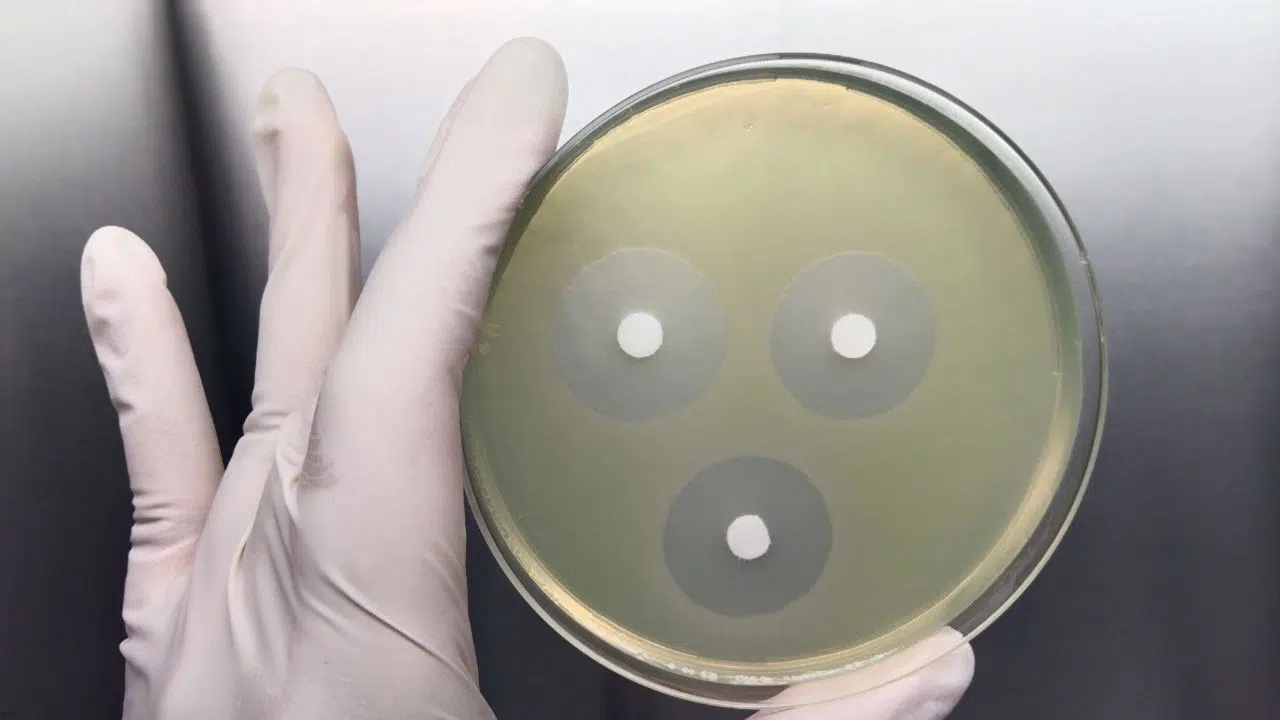
Découverte d'une nouvelle classe antibiotiques grâce à l'IA Découverte d'une nouvelle classe antibiotiques grâce à l'IA

Une révolution dans la lutte contre la résistance aux antibiotiques
La résistance aux antibiotiques est un défi majeur de la santé publique mondiale. Dans ce contexte, une avancée significative a été réalisée par une équipe internationale de chercheurs. Ils ont développé une méthode innovante basée sur l’apprentissage profond explicable pour découvrir de nouvelles classes structurales d’antibiotiques.
La méthodologie: Combiner la chimie et l’IA
La méthode mise au point repose sur l’identification des sous-structures chimiques associées à l’activité antibiotique. Les chercheurs ont analysé les profils d’activité antibiotique et de cytotoxicité humaine de 39,312 composés. Ensuite, ils ont appliqué des ensembles de réseaux neuronaux graphiques pour prédire l’activité antibiotique et la cytotoxicité de plus de 12 millions de composés.
Journée européenne d’information sur les antibiotiques : le 18 novembre 2023
Un processus d’exploration chimique guidé par IA
L’approche innovante permet d’explorer efficacement l’espace chimique en se basant sur des algorithmes graphiques explicables. Ces algorithmes identifient les sous-structures responsables d’une forte activité antibiotique et d’une faible cytotoxicité prévue.
Des résultats prometteurs
Sur 283 composés testés empiriquement, plusieurs ont montré une activité antibiotique contre Staphylococcus aureus, notamment contre des souches résistantes à la méthicilline (MRSA) et à la vancomycine. Cette découverte est cruciale car S. aureus est un pathogène résistant à de nombreux antibiotiques de première ligne.
Une nouvelle classe d’Antibiotiques
Parmi les classes structurales identifiées, une s’est révélée sélective contre MRSA et a montré une capacité à réduire les titres bactériens dans des modèles de souris infectées par MRSA. Cette classe structurale représente un espoir considérable dans la lutte contre les infections résistantes aux antibiotiques.
Implications et perspectives
Cette recherche démontre que les modèles d’apprentissage machine dans la découverte de médicaments peuvent être explicables et fournir des aperçus importants sur les sous-structures chimiques qui sous-tendent l’activité sélective des antibiotiques.
Un pas en avant dans la médecine
Cette approche marque un tournant dans la découverte d’antibiotiques, offrant une méthode pour exploiter la diversité structurelle de l’espace chimique de manière plus efficace et ciblée. C’est une avancée majeure dans la course contre l’émergence continue de la résistance aux antibiotiques.
Cette découverte ouvre la voie à de nouvelles stratégies pour combattre les infections bactériennes résistantes. Elle illustre parfaitement comment l’intégration de l’intelligence artificielle et de la chimie peut conduire à des avancées significatives en médecine. Avec ces nouvelles classes d’antibiotiques, l’espoir est renouvelé pour surmonter l’un des plus grands défis de la santé publique au 21e siècle.
Source de l'article : Wong, F., Zheng, E.J., Valeri, J.A. et al. Discovery of a structural class of antibiotics with explainable deep learning. Nature (2023). https://doi.org/10.1038/s41586-023-06887-8